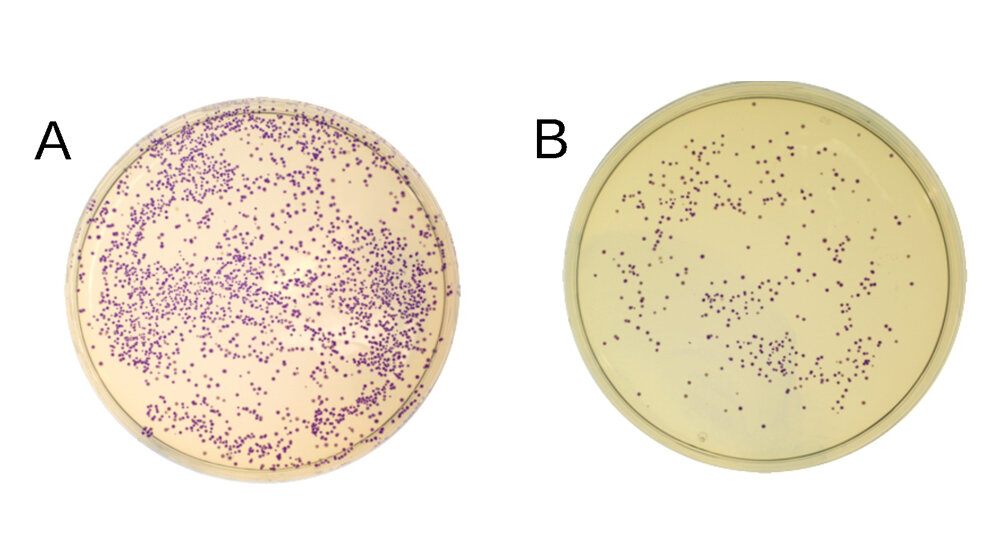
E_Coli_Bakterien_die_blaues_Protein_produzieren_Fotos_David_Oliver_Richter.jpg E. Coli-Bakterien, die blaues Protein produzieren

Allen Verfahren, die derzeit zur Klonierung eingesetzt werden, ist gemeinsam, dass DNA-Fragmente zunächst in größere Trägermoleküle, sogenannte Vektoren, eingebaut werden. Die mit DNA-Fragmenten beladenen Vektoren werden anschließend in Bakterien eingeschleust. Indem sich die Bakterien vermehren und so eine Bakterienkolonie bilden, werden die DNA-Fragmente tausendfach vervielfältigt. Bisher haben diese Verfahren einen wesentlichen Nachteil: Weil der Einbau von DNA-Fragmenten in das Trägermolekül nicht immer störungsfrei und mit der nötigen Perfektion gelingt, besitzen keineswegs alle, sondern nur einige Kolonien die Vektoren mit den zu vervielfältigenden DNA-Fragmenten. Um diese „Erfolgsfälle“ zu identifizieren, war bisher ein zeitaufwändiges und teures Screening unvermeidlich.
Screening wird überflüssig
Den Forschern der Universität Bayreuth unter der Leitung von Prof. Dr. Stefan Schuster ist es jetzt gelungen, dieses Screening überflüssig zu machen. Bei dem von ihnen verwendeten Vektor handelt es sich um ein Plasmid, das in seiner Ringstruktur ein toxisches Gen enthält. DNA-Fragmente werden nun so in das Plasmid eingebaut, dass sie dieses Gen ersetzen. Gelingt das nicht, bleibt das toxische Potenzial im Plasmid erhalten. Wird in einem solchen Fall das Plasmid in ein E. coli-Bakterium eingeschleust, setzt die toxische Wirkung ein: Sie führt dazu, dass das Bakterium vermehrungsunfähig wird und nicht lange überlebt. Dadurch ist von vornherein gewährleistet, dass nur solche E. coli-Bakterien Kolonien bilden, in denen die DNA-Fragmente tatsächlich enthalten sind. Sie müssen nicht nachträglich mühevoll ausgelesen werden.
Auslese erfolgt von selbst
„Unser neues Klonierungssystem ist vor allem deshalb so effizient, weil die Auslese der mit klonierten DNA-Fragmenten ausgestatteten Bakterien zuverlässig von selbst erfolgt. Die vervielfältigten Plasmide können aus diesen Bakterien isoliert und weiterverwendet werden – sei es, um die klonierte DNA zu analysieren oder um sie für die biotechnologische Herstellung von Proteinen einzusetzen“, sagt der Bayreuther Biologe Dr. David Richter, Erstautor der Studie.
„Klebstoff“ für mehrere DNA-Fragmente
Das vorgestellte Verfahren vereinfacht den Vorgang der Klonierung noch in einer weiteren Hinsicht: Die Wissenschaftler haben eine aus den Zellen von E. coli-Bakterien gewonnenen Extrakt (SLiCE) so optimiert, dass er sich hervorragend als „Klebstoff“ eignet, um mehrere DNA-Fragmente wie die Glieder einer Kette aneinanderzureihen und zu verbinden. So können jetzt die verschiedensten Kombinationen von DNA-Fragmenten in das Plasmid eingefügt werden. Dies ist deutlich schneller als mit bisherigen Methoden.
Klonierungssystem heißt „ZeBRα“
Das Bayreuther Forscherteam hat das neue Klonierungssystem auf den Namen „ZeBRα“ getauft. Das Akronym leitet sich von den wissenschaftlichen Bezeichnungen zweier Faktoren ab, die dabei entscheidend sind. Das verwendete Plasmid ist ein „Zero-Background Vector“. Dies bedeutet: Bakterien, die Plasmid-Moleküle ohne die zu vervielfältigenden DNA-Fragmente enthalten, bilden keine störenden Kolonien im Hintergrund. „Redα-Exonuclease“ ist wiederum ein Bestandteil des E. coli-Extracts, mit dem verschiedene DNA-Fragmente aneinandergekettet und in den Vektor eingebaut werden können.
Klonierungsverfahren soll vielseitiger einsetzbar werden
Anknüpfend an die jetzt veröffentlichten Forschungsergebnisse wollen die Wissenschaftler ihr Klonierungsverfahren künftig um weitere Funktionen bereichern und dadurch vielseitiger einsetzbar machen. Insbesondere soll der Vektor so optimiert werden, dass er die Transformation bestimmter Organismen oder Zelllinien erleichtert. Dabei werden DNA-Fragmente direkt in Organismen oder Zellen übertragen. Weil auch diese Übertragung relativ selten zustande kommt, ist es vorteilhaft, wenn der Vektor DNA-Sequenzen mitbringt, die zur Bildung fluoreszierender Proteine führen. Diese Proteine machen dann den erfolgreichen Einbau der DNA-Fragmente sichtbar. (idw, red)
David Richter, Katharina Bayer, Thomas Toesko, Stefan Schuster: ZeBRα a universal, multi-fragment DNA-assembly-system with minimal hands-on time requirement. Scientific Reports 9 (2019), DOI: dx.doi.org/10.1038/s41598-019-39768-0.
Artikel teilen